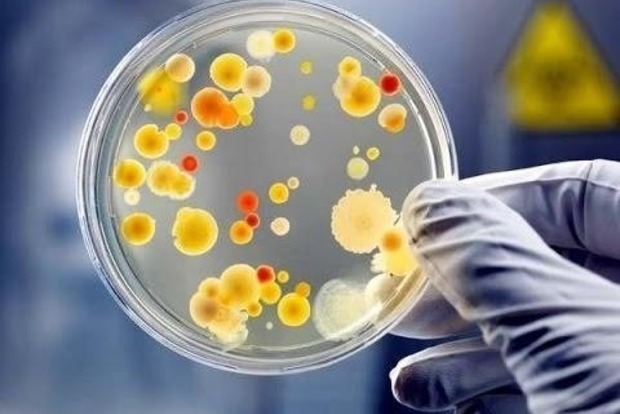

На Мадагаскаре бушует эпидемия легочной чумы: уже 100 жертв
Просмотров:
65
На острове Мадагаскар вспышка легочной чумы. От нее умерли уже 94 человека. Об этом сообщает агентство Reuters со ссылкой на Всемирную организацию здравоохранения(ВОЗ).
Как сообщается, с 1 августа по 20 октября 2017 года на Мадагаскаре зарегистрировали 1 153 случая подозрения на чуму, из них 300 - подтверждены лабораторными тестами. На остров привезли антибиотиков для лечения почти 5 тысяч человек и больше 150 тыс. наборов со средствами индивидуальной защиты.
Стоит отметить, что болезнь могла "выйти" за пределы Мадагаскара. "Это вызывает особую тревогу, так как эпидемия началась раньше обычного и преимущественно поражала города, а не сельские районы", - говорится в сообщении.
Новости партнеров
Другие важные новости и публикации
Еще интересное
/-1,0857980251312-/
/-pc-/
Top




 .
.


 .
.




























